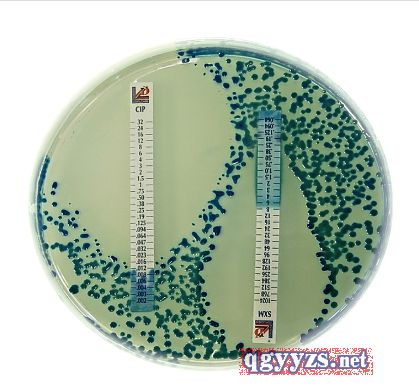

意大利利飛馳的MIC卡
發布時間:2020/10/13 15:39:54 瀏覽次數:67
溫馨提醒:請仔細閱讀產品說明書,禁忌內容或者注意事項詳見說明書。
| 產品名稱 | 意大利利飛馳的MIC卡 |
| 品牌名稱 | 意大利利飛馳 |
| 注冊商標 | 意大利利飛馳 |
| 產品用途 | iofilchem®MIC試紙梯度定量試紙是一種用于確定抗菌藥物抗微生物的*小抑菌濃度(M.I.C.)和檢測耐機制的定量檢測產品。意大利利飛馳提供的M.I.C梯度定量(專利號:1395483)參比方法是常規紙片法和瓊脂(肉湯)稀釋法的完美升級...可提供多種包裝規格:10/30/100條每包裝。 |
| 作用機理 | 1.ISO13485資質制造,產品**獲得CE認證 2.高質量梯度定量檢測試紙準確預設了15種對倍稀釋的抗生素藥物濃度 3.行業公認的苛養菌和罕見菌藥敏實驗標準方法 4.提供準確的M.I.C值,不受折點設定限制 5.無需額外任何設備儀器限制;結果簡單明了快速 |
| 產品規格 | 100條/盒 |
| 零售價格 | 面議 |
| 供貨價格 | 面議 |
| 產品賣點 | Liofilchem®MIC試紙梯度定量試紙是一種用于確定抗菌藥物抗微生物的*小抑菌濃度(M.I.C.)和檢測耐機制的定量檢測產品。意大利利飛馳提供的M.I.C梯度定量(專利號:1395483)參比方法是常規紙片法和瓊脂(肉湯)稀釋法的完美升級...可提供多種包裝規格:10/30/100條每包裝。 產品特點 1.ISO13485資質制造,產品**獲得CE認證 2.高質量梯度定量檢測試紙準確預設了15種對倍稀釋的抗生素藥物濃度 3.行業公認的苛養菌和罕見菌藥敏實驗標準方法 4.提供準確的M.I.C值,不受折點設定限制 5.無需額外任何設備儀器限制;結果簡單明了快速 適用范圍 1.適用于醫院檢驗科微生物室2.各臨床試驗室 3.制藥企業實驗室4.科研機構實驗室5.食品、畜牧、獸醫等檢測實驗室 |
| 補充說明 | 濮陽華福商貿有限公司 主要代理意大利利飛馳的MIC卡 |